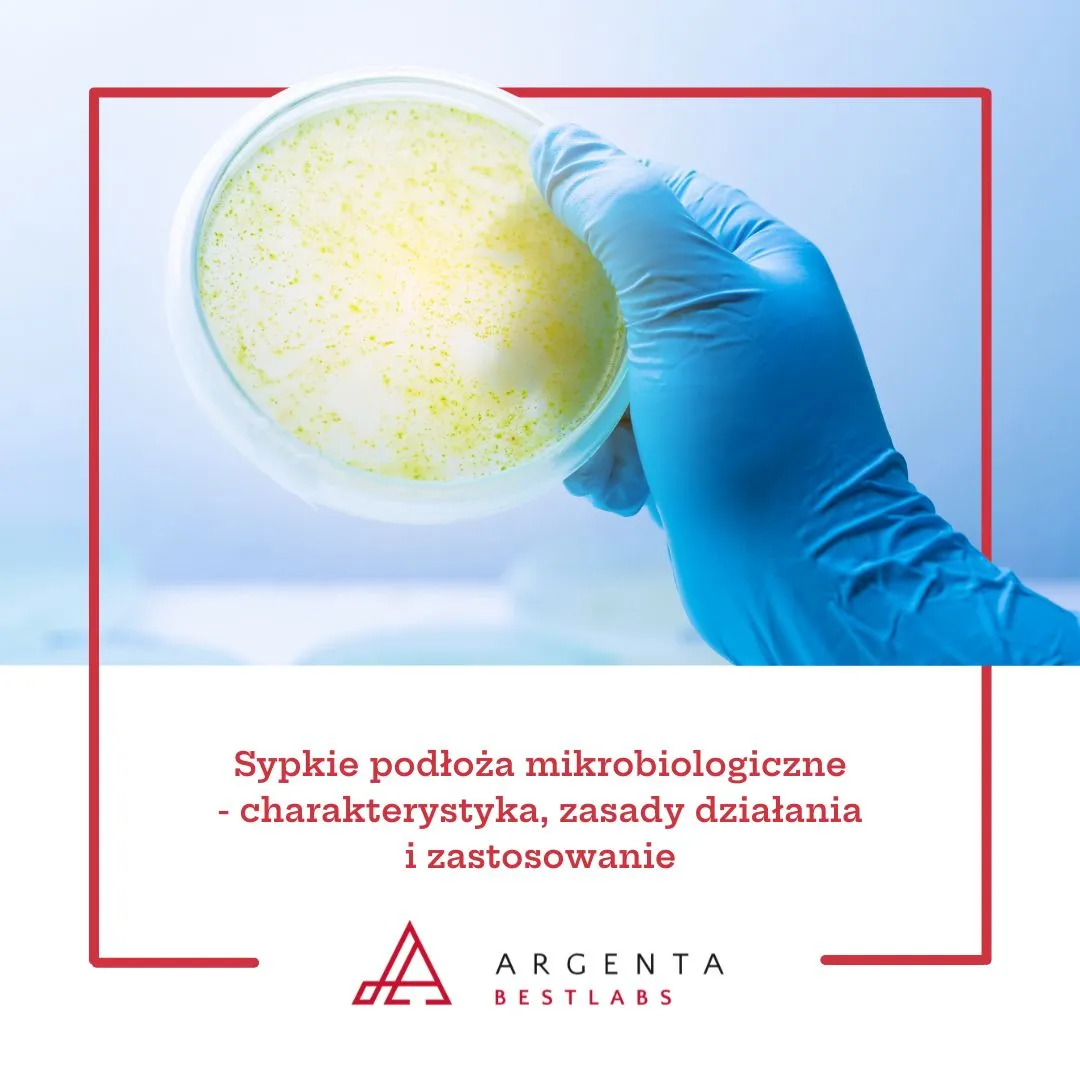
Sypkie podłoża mikrobiologiczne - charakterystyka, zasady działania i zastosowanie w mikrobiologii

Podłoża sypkie stanowią ważną grupę podłóż mikrobiologicznych, oferowaną w postaci proszków odwodnionych. Przed wykorzystaniem wymagają przygotowania w laboratorium poprzez rozpuszczenie w wodzie i sterylizację. Taka forma umożliwia elastyczne dopasowanie ilości i stężenia medium do potrzeb badawczych oraz pozwala na stosowanie dodatków selektywnych zgodnie z metodyką. Podłoża sypkie znajdują zastosowanie w diagnostyce mikrobiologicznej, badaniach środowiskowych oraz w systemach kontroli jakości.
Czym są podłoża sypkie?
Podłoża w formie sypkiej to media mikrobiologiczne oferowane jako odwodnione proszki, które po odpowiednim przygotowaniu tworzą płynne lub stałe pożywki dla drobnoustrojów. Ich główną cechą jest możliwość przygotowania roztworu dokładnie według wymagań procedury laboratoryjnej. Dzięki temu laboratoria mogą zapewnić spójność procesów badawczych i uzyskać pożywki zgodne z obowiązującymi normami.
Rodzaje podłóż sypkich i mechanizmy ich działania
- Podłoża odżywcze - zawierają źródła węgla, azotu oraz sole mineralne. Tworzą środowisko wspierające namnażanie szerokiego spektrum mikroorganizmów, dostarczając podstawowych składników pokarmowych.
- Podłoża selektywne - zawierają substancje hamujące wzrost niektórych grup bakterii, np. barwniki, sole żółciowe czy antybiotyki. Dzięki temu umożliwiają izolację wybranych drobnoustrojów spośród mieszaniny mikroorganizmów.
- Podłoża różnicujące - wzbogacone o wskaźniki biochemiczne (np. barwniki pH, substraty fermentacyjne), pozwalają na obserwację cech metabolicznych i odróżnienie kolonii na podstawie ich właściwości biochemicznych.
- Podłoża chromogenne - zawierają specjalne substraty barwne, które w reakcji z enzymami drobnoustrojów zmieniają kolor kolonii, co ułatwia wizualną identyfikację.
- Podłoża specjalistyczne - projektowane do hodowli określonych grup mikroorganizmów, np. bakterii beztlenowych, drożdży czy pleśni, a także patogenów o specyficznych wymaganiach wzrostowych.
Zastosowanie w laboratoriach
Podłoża sypkie są stosowane w wielu obszarach mikrobiologii. Wykorzystuje się je m.in. do:
- izolacji i namnażania mikroorganizmów,
- różnicowania gatunków i szczepów na podstawie cech metabolicznych,
- przeprowadzania analiz jakościowych i ilościowych w badaniach żywności, wody i próbek środowiskowych,
- monitoringu higieny w środowiskach produkcyjnych i diagnostycznych,
- procedur zgodnych z metodami referencyjnymi i normami branżowymi (ISO, EUCAST, CLSI, HACCP, GMP).
Zasady przygotowania i przechowywania
Podłoża sypkie wymagają przygotowania zgodnego z instrukcją producenta i protokołami laboratoryjnymi. Typowe etapy obejmują:
- odmierzanie proszku w ilości przewidzianej w procedurze,
- rozpuszczenie w wodzie destylowanej lub dejonizowanej,
- mieszanie do uzyskania jednorodnego roztworu,
- sterylizację w autoklawie przed dalszym użyciem.
Proszki należy przechowywać w suchym miejscu, w szczelnie zamkniętym opakowaniu, chroniąc przed dostępem wilgoci i zanieczyszczeniami. Dokumentacja laboratoryjna powinna uwzględniać numery partii, daty przygotowania oraz okresy przydatności pożywek.
Przykładowe podłoża sypkie dostępne na Bestlabs
Kategoria podłóż sypkich na Bestlabs obejmuje szeroką gamę mediów w formie proszkowej. Poniżej znajdują się przykłady produktów dostępnych w ofercie Bestlabs:
- Sodium Chloride Bacteriological 500 g
- Phosphate Buffered Saline Tabletki soli fizjologicznej buforowane fosforanami
- Nutrient Broth 500 g
- MacConkey Agar 500 g
Zobacz podłoża sypkie na Bestlabs
Podłoża sypkie są wszechstronną kategorią mediów mikrobiologicznych, obejmującą podłoża odżywcze, selektywne, różnicujące, chromogenne i specjalistyczne. Dzięki formie proszkowej laboratoria mogą przygotowywać pożywki zgodnie z aktualnymi potrzebami, zachowując kontrolę nad ilością i składem medium.
Niektóre z produktów dostępnych w tej kategorii to wyroby medyczne przeznaczone wyłącznie do użytku profesjonalnego, zgodnie z art. 2 pkt 1.26 Ustawy o wyrobach medycznych. Produkty te nie są przeznaczone do stosowania w warunkach domowych. Szczegółowe informacje o przeznaczeniu, zastosowaniu oraz zasadach zakupu znajdują się na stronie produktu w sklepie bestlabs.pl.